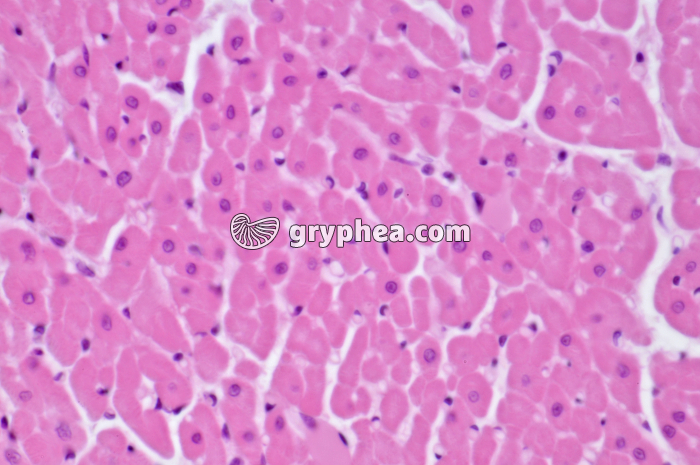
Mucle cardiaque CT x160 - gryphea.com

Type : Photographie
Référence : XN 30090-41
Auteur : Hervé Conge
Edition et PresseNumérique et Internet
Valeur du crédit
1 crédit = 6.00€ TTC
(Hors pack)
1 crédit = 6.00€ TTC
(Hors pack)
si vous êtes enseignant, le site gryphea.org a été conçu spécialement pour vous !
Edition et Presse
Paramètres additionnels
Tirage
Distribution
Durée d'utilisation
Droits numériques en sus
Total : crédits
Ajouter au panier
Numérique et Internet
Paramètres additionnels
Numérique
Internet
Durée d'utilisation
Total : crédits
Ajouter au panier
Numérique et Internet
Paramètres additionnels
Numérique
Internet
Durée d'utilisation
Total : 4 crédits
Ajouter au panier
Légende :
La suite du commentaire est réservée aux inscrits, créez un compte gratuitement.
Le muscle cardiaque est un muscle strié, au fonctionnement autonome, et n’existe que dans le coeur. Les cellules de ce muscle particulier présentent un noyau central unique, et des ramifications s’interconnectant avec les cellules voisines.
La suite du commentaire est réservée aux inscrits, créez un compte gratuitement.
Thèmes associés :
Système musculo-squelettique